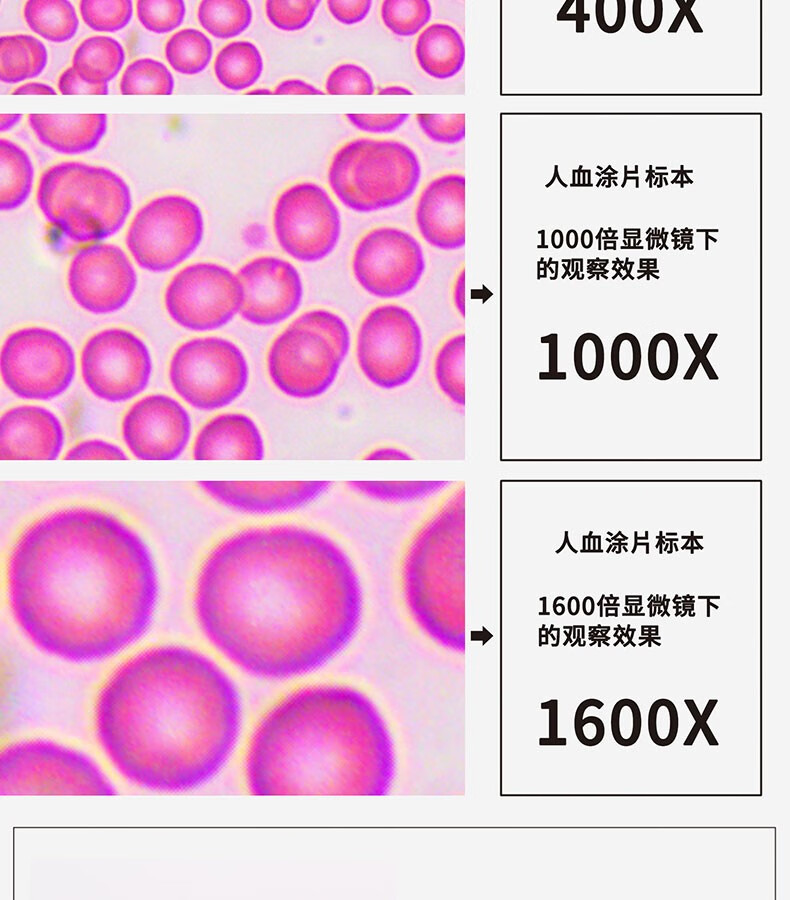

溫馨提示 本商品無(wú)質(zhì)量問(wèn)題不支持退換貨
鳳凰 望遠(yuǎn)鏡Phenix10x50高倍高清微光夜視雙筒望遠(yuǎn)鏡
¥271.60鳳凰 望遠(yuǎn)鏡Phenix12x50高清高倍微光夜視雙筒望遠(yuǎn)鏡
¥281.30鳳凰 Phenix 8-24x50 雙筒保羅式變倍高清望遠(yuǎn)鏡 可調(diào)遠(yuǎn)近
¥310.40鳳凰 Phenix PH20-1A31L-A 單目生物顯微鏡640倍高倍高清家用實(shí)驗(yàn)教學(xué)
¥678.00鳳凰 Phenix XSP-35單目生物顯微鏡專業(yè)光學(xué)640高倍學(xué)生科普養(yǎng)殖檢測(cè)
¥1163.03